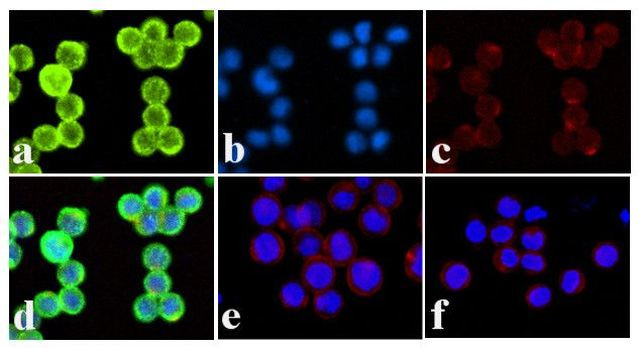
Phospho-INSR (Tyr1328) Antibody in Immunocytochemistry (ICC/IF)

Search
Invitrogen
Phospho-INSR (Tyr1328) Polyclonal Antibody
{{$productOrderCtrl.translations['antibody.pdp.commerceCard.promotion.promotions']}}
{{$productOrderCtrl.translations['antibody.pdp.commerceCard.promotion.viewpromo']}}
{{$productOrderCtrl.translations['antibody.pdp.commerceCard.promotion.promocode']}}: {{promo.promoCode}} {{promo.promoTitle}} {{promo.promoDescription}}. {{$productOrderCtrl.translations['antibody.pdp.commerceCard.promotion.learnmore']}}
图: 1 / 3
Phospho-INSR (Tyr1328) Antibody (44-807G) in ICC/IF



产品信息
44-807G
种属反应
已发表种属
宿主/亚型
分类
类型
抗原
偶联物
形式
纯化类型
保存液
内含物
保存条件
运输条件
RRID
靶标信息
INSR is a receptor tyrosine kinase. Binding of insulin to the extracellular domain of INSR stimulates glucose uptake. INSR and IGF-1 receptors share major structural and functional similarity. The earliest cellular response to insulin stimulation is autophosphorylation of tyrosine in INSR. In humans, the INSR gene is located on chromosome 19. Defects in INSR are the cause of various insulin resistance syndromes and IGF-1R defects may also cause some forms of growth retardation.
仅用于科研。不用于诊断过程。未经明确授权不得转售。
生物信息学
蛋白别名: CD 220; CD220; CD220 antigen; CD220 beta; CD221; HHF 5; IGF-I receptor; Insulin receptor; insulin receptor precursor; IR; IR 1; IR beta; IR-1; IR1; unnamed protein product
基因别名: CD220; HHF5; INSR
UniProt ID: (Human) P06213
Entrez Gene ID: (Human) 3643